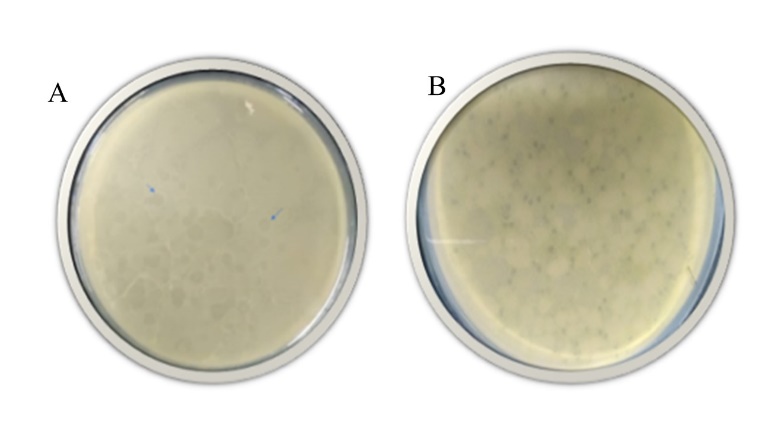

Determinación del efecto antagónico de bacteriófagos sobre géneros de bacterias potenciales causantes de mastitis bovina (Staphylococcus spp., Streptococcus spp., Corynebacterium spp., Pseudomonas spp., y Escherichia coli) en Pamplona, Norte de Santander
DOI:
https://doi.org/10.24054/cyta.v4i2.1040Palabras clave:
control alternativo, resistencia bacteriana, infección de la ubre, fagosResumen
En el presente trabajo se determinó el efecto antagónico de bacteriófagos sobre bacterias potenciales causantes de mastitis bovina como Staphylococcus spp., Streptococcus spp., Corynebacterium spp., E. coli y Pseudomona spp. Se analizaron dos muestras, una del hisopado de la ubre y otra de la leche de una vaca con mastitis. Se empleó el protocolo de aislamiento de doble capa de agar y se observó la presencia de fagos infectando a Staphylococcus spp., E. coli y Pseudomonas spp. Los bacteriófagos son una prometedora alternativa a los antibióticos, compuestos a los cuales las bacterias han desarrollado algún tipo de resistencia.
Descargas
Referencias
Abedon, S.T. y Culler, R.R. (2007). Optimizing bacteriophage plaque fecundity. J Theor Biol 249: 582-592.
Angelopoulou, A., Warda, A., Hill, C. y Ross, P. (2019). Nonantibiotic microbial solutions for bovine mastitis – live biotherapeutics, bacteriophage, and phage lysins. Critical Reviews in Microbiology, DOI: 10.1080/1040841X.2019.1648381
Carson, L., Gorman, S.P. y Gilmore, B.F. (2010). The use of lytic bacteriophages in the prevention and eradication of biofilms of Proteus mirabilis and Escherichia coli. FEMS Immunol. Med. Microbiol. 59:447-455.
Cisek, A., Dabrowska, I., Gregorczyk, K., y Wyzewski G. (2017). Phage Therapy in Bacterial Infections Treatment: One Hundred Years After the Discovery of Bacteriophages. Curr Microbiol, 74:277-283. DOI 10.1007/s00284-016-1166-x
Gomes, F. y Henriques, M. (2016). Control of Bovine Mastitis: Old and Recent Therapeutic Approaches. Curr Microbiol 72:377–382. DOI 10.1007/s00284-015-0958-8
Hesse, S. y Adhya, S. (2019). Phage Therapy in the Twenty-First Century: Facing the Decline of The Antibiotic Era; Is it Finally Time for The Age of the Phage? Annu. Rev. Microbiol. 73:7.1–7.20 The Annual Review of Microbiology is online at micro.annualreviews.org https://doi.org/10.1146/annurev-micro-090817-062535
Horiuk, Y.V. (2018). Phagotherapy of cow's mastitis as an alternative to antibiotics in the system of obtaining environmentally safe milk. Scientific Messenger of Lviv National University of Veterinary Medicine and Biotechnologies, 20(88): 42-47. doi: 10.32718/nvlvet8807.
Kropinski, A.M., Mazzocco, A., Waddell, T.E., Linghor, E., y Johnson, R.P. (2009). Enumeration of bacteriophages by double agar overlay plaque assay. Methods in Molecular Biology. 501:69-76. doi: 10.1007/978-1-60327-164-6_7. http://www.springerprotocols.com/Abstract/doi/10.1007/978-1-60327-164-6_7
Leite, J.A., Pereira, H.P., Borges, C.A.V.; Alves, B.R.C., Ramos, A.I.A.P., y Martins, M.F.; Arcuri, E.F. (2019). Lytic bacteriophages as a potential alternative to control Staphylococcus aureus. Pesquisa Agropecuária Brasileira, v.54, e00917. DOI: https://doi.org/10.1590/S1678-3921.pab2019.v54.00917.
Malik, D., Sokolov I., Vinner, G., Mancuso, F., Cinquerrui, S., Vladisavljevic, G., Clokie, M., Garton, N., Stapley, A., y Kirpichnikova, A. (2017). Formulation, stabilisation and encapsulation of bacteriophage for phage therapy. Advances in Colloid and Interface Science 249 100–133. http://dx.doi.org/10.1016/j.cis.2017.05.014
O’Flaherty, S., Coffey, A., Meaney, W.J., Fitzgerald, G.F., y Ross, R.P. (2005). Inhibition of bacteriophage K proliferation on Staphylococcus aureus in raw bovine milk. Lett Appl Microbiol 41:274-279.
Oliver, S. y Murinda, S. (2012). Antimicrobial Resistance of Mastitis Pathogens. Vet Clin Food Anim. 28:165-185. http://dx.doi.org/10.1016/j.cvfa.2012.03.005
Descargas
Publicado
Número
Sección
Licencia
Derechos de autor 2019 Vega, T. Liliana, Márquez C. Ana, de la Cruz A. Boris, Torres C. Angie, Ricardo P. Alba

Esta obra está bajo una licencia internacional Creative Commons Atribución-NoComercial-CompartirIgual 4.0.









